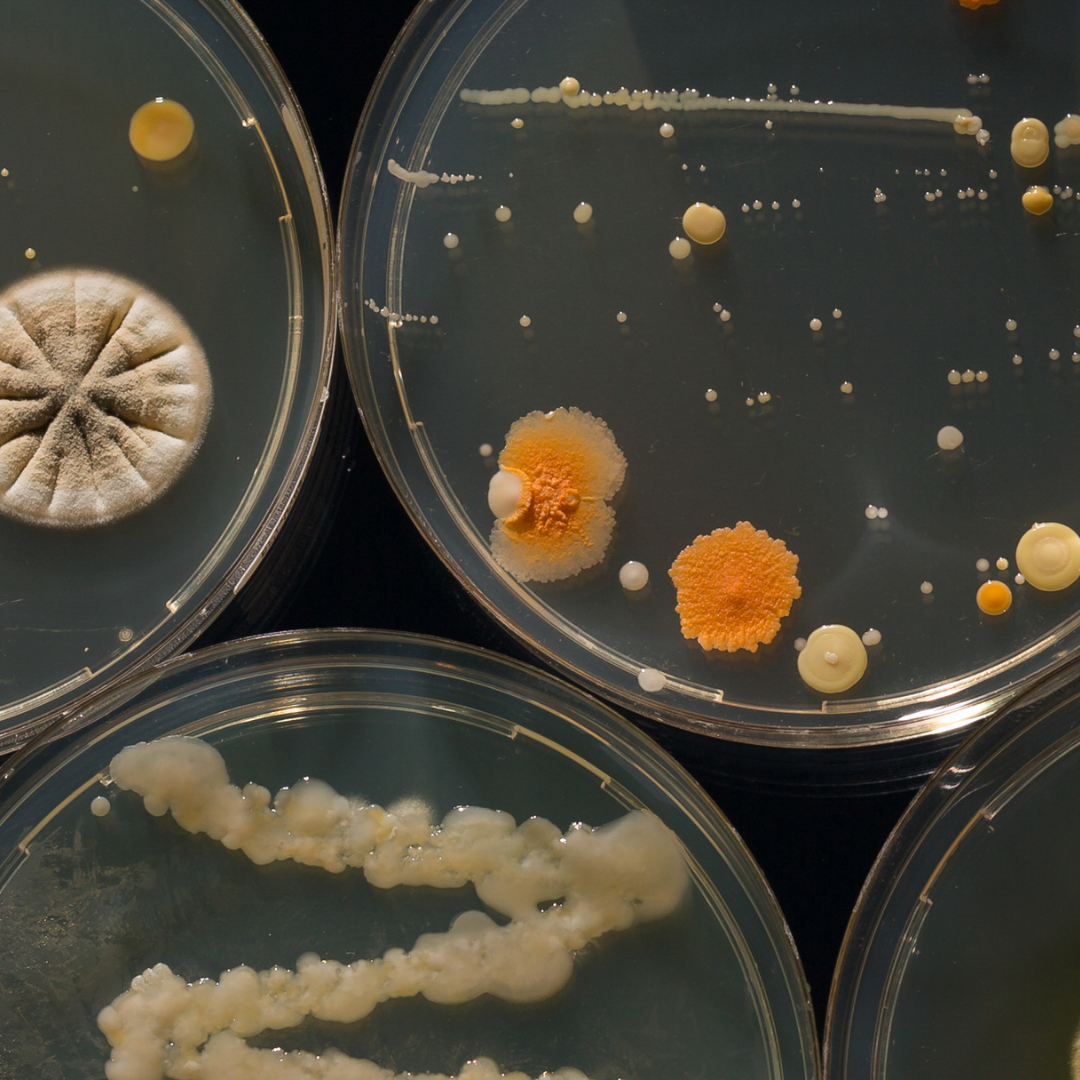
Manufacturing Practices: How immy is Revolutionizing Gut Health with CPI

immy Health Journal

How Your Sleep Habits Shift As Daylight Disappears

How the Holidays Impact Your Stress

What Sleep Really Does to Your Testosterone (and How to Get Yours Back on Track)

Slow Living in a Fast World

Nature
The Benefits of Trading Treadmills for Trails

Urban Green Spaces

Should You Rotate Supplements? Here’s How to Do It Smartly

Immunity
Seasonal Immune Rhythms: Why Fall Makes Us Sick

How Microbes Build (or Break) Your Child's Immune System

Modern Life
How Artificial Light Can Trigger Inflammation (And Nature’s Fix)

Gut Health, Inflammation
The Root to Gut Pipeline: How Soil Health Affects Inflammation

Gut Health
An Ancient Idea, Reborn: Why Gut Support Matters in Medicine World

Nature
Green Spaces, Healthy Places

Inflammation
The Anti-Inflammatory Diet: Your Guide to Better Health

Gut Health
What Is Rewilding the Microbiome, Really?

Modern Life
How Microplastics Are Compromising Your Immune System

Stress
How Constant Stress Damages Your Cells

Inflammation
The Link Between Inflammation and Asthma, Allergies, and Depression

Immunity
Inside Dr. Charles Akle’s Holistic Approach to Immune Health and Cancer Care

Immunity
Why Are Cancer Rates Rising in Young Adults?

Immunity
A Research Review of Mycolicibacteria in Cancer Treatment

Immunity
The Ancient Secret to Modern Immunity (And How Your Pets Are Affecting Your Health)

Immunity
How Microbiome Health Affects Cancer Risk and Treatment

News
What Yahoo Had to Say About Immune Support for Dads on the Go

Immunity
Why Cancer Rates are Rising

News
The Hidden Health Challenge of Travel

Gut Health
Microplastics, Gut Health & How to Fight Back

Immunity
Get to Know Dr. Charles Akle

Inflammation
The Gut-Hormone Connection: How Your Microbiome Shapes Testosterone, Estrogen, and Metabolic Health

Inflammation, Longevity
Energizing Your Cells: How Gut Health and Mitochondria Shape Aging and Vitality

Longevity
Change How You Age Forever

Longevity
Can Gut Health Protect Your Brain? Exploring the Link to Memory and Alzheimer's

Mental Health
Understanding the Connection Between Gut Health and Mental Health

Sleep
Could Healthy Bacteria Improve Your Sleep Quality?

Inflammation
Fighting Inflammation in the Vagus Nerve

Gut Health
Is Your Gut the Key to Better Mental Health?

Gut Health
The Lung-Gut Axis

Diet
Western Diet, Inflammation, and Immune Suppression

Inflammation
Exercise, Gut Health, and Inflammation

Recipe
The Immunity Smoothie Your Gut Will Thank You For

Podcast
Rebuilding Immune Health With Exercise, Diet, and Lifestyle Interventions

Inflammation
How immy Works: The Science of Mycolicibacterium aurum Aogashima

Inflammation
Managing Inflammation with immy: A Game Changer for Cardiovascular Health
Manufacturing
Manufacturing Practices: How immy is Revolutionizing Gut Health with CPI

Inflammation
The Devastating Effects of Chronic Inflammation

Podcast
immy: The Future of Immune Health and Chronic Inflammation Management

News
immy™ Featured in mindbodygreen: a Breakthrough in Bacterial Health

News












